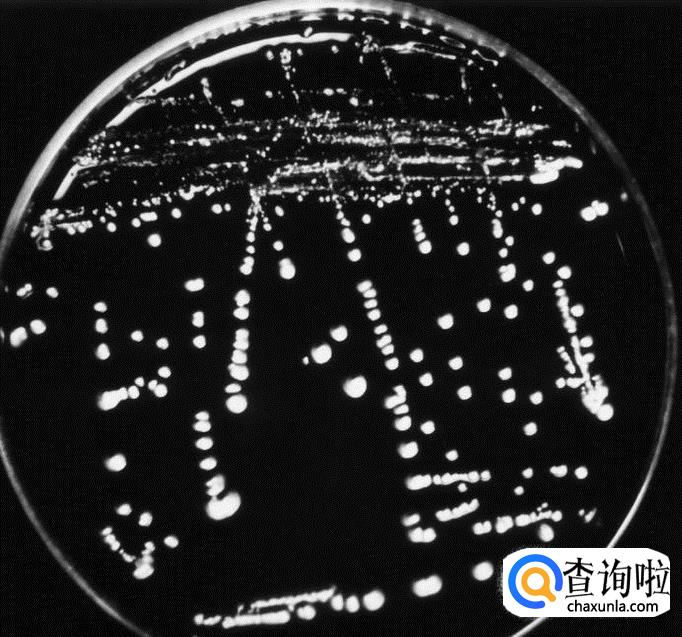
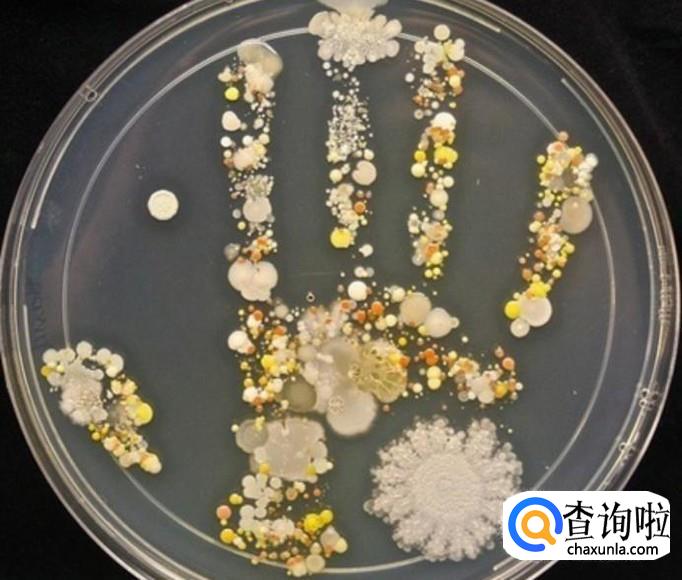
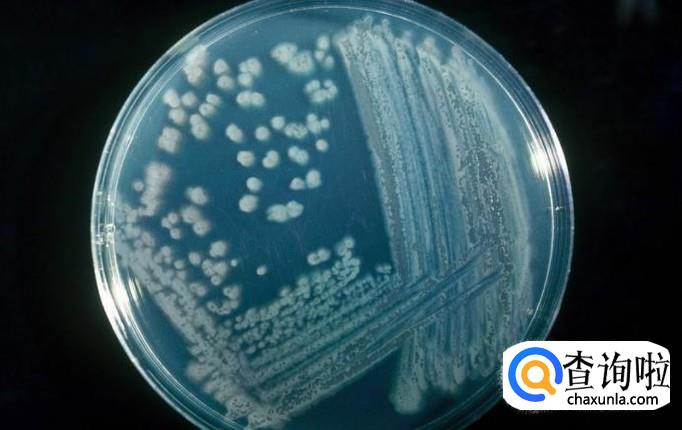

最佳回答
本文由作者推荐
简要回答
在初中生物中,我们要了解什么是真菌和细菌,所以在章节学习中我们学习到了菌落,菌落就是细菌或真菌繁殖后形成肉眼可见的集合体,下面小编就给大家讲讲真菌和细菌菌落的区别是什么。
详细内容
- 01
首先通过肉眼直接观察可以看出,细菌菌落比较小,而真菌的菌落相对要大一些。细菌的菌落要仔细观察才能够看见。
- 02
在颜色方面,细菌的菌落一般是白色,透明,黄色,细菌的颜色比较淡。而真菌的颜色非常多,更加丰富。真菌一般有绿色,黑色,褐色,黄色,绿色等多种颜色。
- 03
在形态方面,细菌菌落表面一般光滑粘稠,不然就是粗糙干燥。而真菌确实毛茸茸的,或者像蜘蛛网一样,甚至还有絮状的。
- 04
正确区分细菌菌落和真菌菌落,不仅能够更好地学习生物,也非常有利于日常生活。像我们生活中橘子发霉,橘子表面就是真菌菌落。

广告位
点击排行
- 2 排行
- 3 排行
- 4 排行
- 5 排行
- 6 排行
- 7 排行
- 8 排行
- 9 排行
- 10 排行
热点追踪
广告位





















